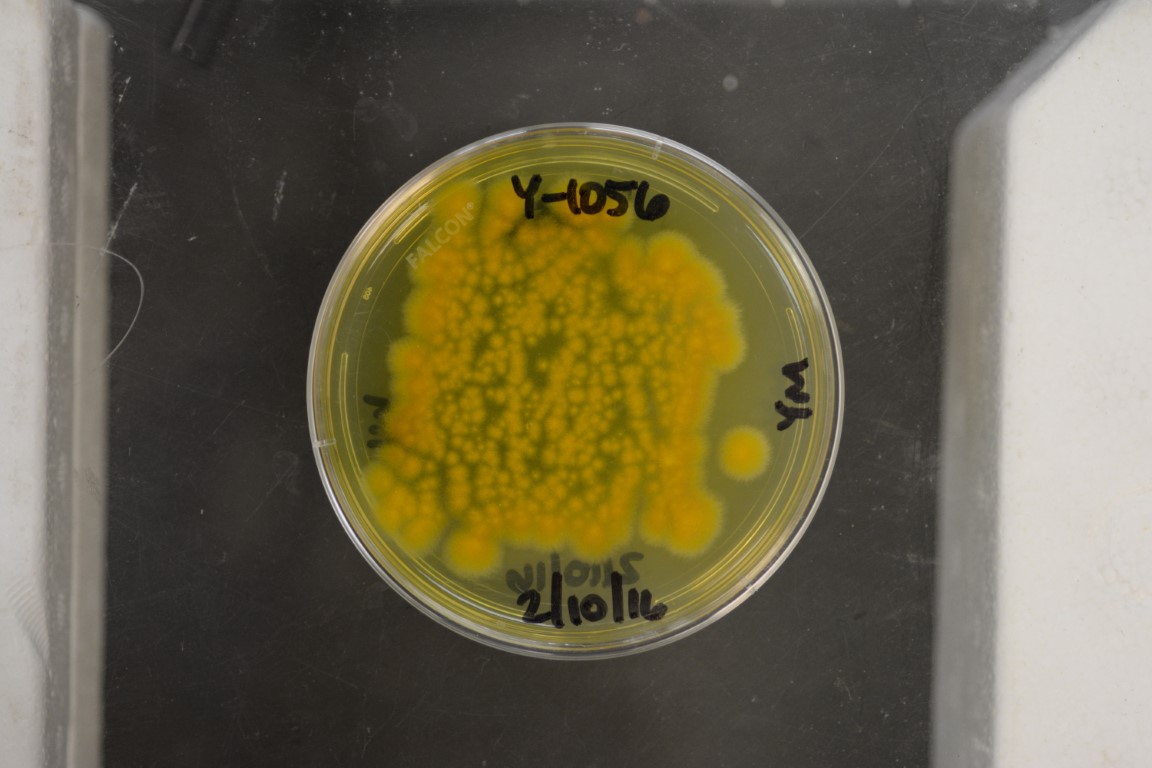

Eremothecium gossypii
NRRL Y-1056
Accession numbers in other collections:ATCC 10895=CBS 109.51=IFO 1355=IGC 4220
Source:Robbins,New York Botanic Gardens,New York City,New York
Isolated from(substrate):unknown
Genetic info:Robnett PCR#54,#87.0 diff.D1/D2,EF,and ITS and 2 diff.MS with Y-1810.GenBank:D1/D2(U43389),SSU(AY046265),ITS(AY046216),mito SSU(AF442349),COXII(AF442273),EF-1 alpha(AF402087).
Growth media:Yeast Extract-Malt Extract-Peptone-Glucose(YM for yeasts)(number 6)
Optimum growth temperature:25C
Strain images:
NRRL_Y-1056_6.jpg

Comments:An authentic or reference strain;no designated type strain.
This strain is a regulated plant pathogen.An APHIS PPQ 526 permit is required for distribution in the United States.For international requests,an importation permit or an official letter from the appropriate government agency declaring that a permit is not required must be provided in advance of shipment.